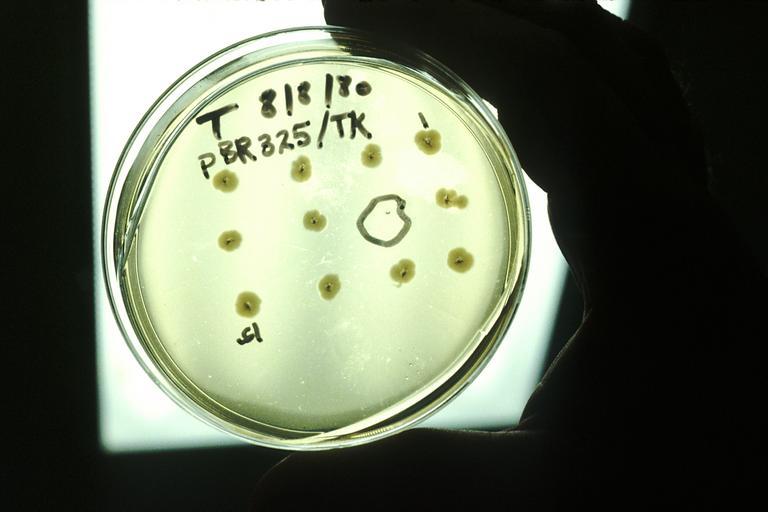

MAKE A MEME
View Large Image
| View Original: | Recombinant DNA.jpg (2700x1800) | |||
| Download: | Original | Medium | Small | Thumb |
| Courtesy of: | commons.wikimedia.org | More Like This | ||
| Keywords: Recombinant DNA.jpg A culture medium and the hands of a technician In this recombinant DNA technology the thymidine kinase gene of herpes simplex virus is being cloned in bacteria Those bacteria that have incorporated the gene are no longer resistant to the antibiotic tetracycline By growing the bacteria on media that includes tetracycline the colonies that don't grow are selected circled in slide These bacteria have incorporated the gene that is being studied Topics/Categories Science and Technology -- Genetics Type Color Photo Source National Cancer Institute Linda Bartlett Photographer 2045 1980 Reuse Restrictions None - This image is in the public domain and can be freely reused Please credit the source and/or author listed above Linda Bartlett Photographer PD-USGov-HHS-NIH Media from National Cancer Institute Visuals Online Images uploaded by Fæ | ||||